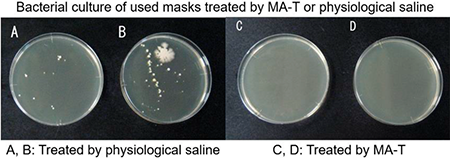

NEWS & TOPICS
Biol. Pharm. Bull. Vol. 45 No. 6
2022/06/01
Sent Date: June 1, 2022
The latest issue of Biol. Pharm. Bull. (BPB)
Vol. 45 No. 6
Current Topics - Recent Advances of GPCR Studies: An Old-Fashioned Perspective?
Foreword
Hiromichi Fujino
Current Topics: Reviews
Pharmacology of Antagonism of GPCR
Hitoshi Kurose and Sang Geon Kim

Non-neuronal Cholinergic Muscarinic Acetylcholine Receptors in the Regulation of Immune Function
Masato Mashimo, Koichiro Kawashima, and Takeshi Fujii

The Biased Activities of Prostanoids and Their Receptors: Review and Beyond
Hiromichi Fujino

Current Topics: Regular Articles
Differential Effects of Gq Protein-Coupled Uridine Receptor Stimulation on IL-8 Production in 1321N1 Human Astrocytoma Cells
Masa-aki Ito, Erika Kojima, Yu Yanagihara, Kazuki Yoshida, and Isao Matsuoka

Identification and Characterization of Human Colorectal Cancer Cluster Predominantly Expressing EP3 Prostanoid Receptor Subtype
Keijo Fukushima and Hiromichi Fujino

Regular Articles
Effects of Concomitant Administration of PXR Ligand Drugs on the Anticoagulant Effects of Warfarin
Ayane Mito, Keiichi Hirono, Haruka Ide, Sayaka Ozawa, Fukiko Ichida, and Masato Taguchi

Comparison of the Concentration of Suspended Particles and Their Chemical Composition near the Ground Surface and Dust Extinction Coefficient by LIDAR
Naoko Honda, Souleymane Coulibaly, Kunihiro Funasaka, Mizuka Kido, Tadashi Oro, Atsushi Shimizu, Takahiro Matsumoto, and Tetsushi Watanabe

Association of Aggression and Antiepileptic Drugs: Analysis Using the Japanese Adverse Drug Event Report (JADER) Database
Kei Kawada, Tomoaki Ishida, Kohei Jobu, Tsuyoshi Ohta, Hitoshi Fukuda, Shumpei Morisawa, Tetsushi Kawazoe, Naohisa Tamura, and Mitsuhiko Miyamura

Discrimination of Malignant Pleural Mesothelioma Cell Lines Using Amino Acid Metabolomics with HPLC
Ryoko Tomita, Nao Nishijo, Tadashi Hayama, and Toshihiro Fujioka

Licochalcone B Induced Apoptosis and Autophagy in Osteosarcoma Tumor Cells via the Inactivation of PI3K/AKT/mTOR Pathway
Zhihui Huang and Genyang Jin

Mechanisms and Safety of Antidepressant-Like Effect of Nutmeg in Mice
Naohiro Iwata, Daisuke Kobayashi, Takehiro Kawashiri, Toshio Kubota, Kotomi Kawano, Yuki Yamamuro, Anna Miyagi, Yuya Deguchi, Takeshi Chijimatsu, and Takao Shimazoe

Carbenoxolone Ameliorates Allergic Airway Inflammation through NF-κB/NLRP3 Pathway in Mice
Fanghan He, Qi Cheng, Na Li, and Yunxiao Shang

Diurnal Changes in Protein Expression at the Blood-Brain Barrier in Mice
Seiryo Ogata, Shingo Ito, Takeshi Masuda, and Sumio Ohtsuki

The Bactericidal Effect of MA-T for Factitiously Contaminated and Used Masks
Ryuta Urakawa, Takekatsu Shibata, Motofumi Sogou, Kiyoto Takamori, Tsuyoshi Inoue, Kiyoshi Konishi, and Takayoshi Sakai
Prediction Accuracy of Area under the Concentration-Time Curve of Vancomycin by Bayesian Approach Using Creatinine-Based Equations of Estimated Kidney Function in Bedridden Elderly Japanese Patients
Akihiro Sonoda, Yoshitaka Iwashita, Yukina Takada, Ryu Hamazono, Kazuhisa Ishida, and Hiroshi Imamura

Possible Involvement of DNA Methylation and Protective Effect of Zebularine on Neuronal Cell Death after Glutamate Excitotoxity
Mayumi Asada, Hideki Hayashi, and Norio Takagi

Role of Mitochondrial Dysfunction in the Pathogenesis of Cisplatin-Induced Myotube Atrophy
Chinami Matsumoto, Hitomi Sekine, Miwa Nahata, Sachiko Mogami, Katsuya Ohbuchi, Naoki Fujitsuka, and Hiroshi Takeda

Notes
Aryl Hydrocarbon Receptor Directly Regulates VTCN1 Gene Expression in MCF-7 Cells
Naoya Yamashita, Kyoko Yoshida, Noriko Sanada, Yuichiro Kanno, and Ryoichi Kizu

A Convenient Assay to Detect Protein Oxidation Caused by Redox-Active Quinones
Nho Cong Luong, Yumi Abiko, Hanako Aoki, and Yoshito Kumagai

Effect of Fatty Acids and Uremic Toxins on the Binding of Nateglinide, an Insulin Secretagogue, to Site II on Human Serum Albumin
Koji Nishi, Ayana Yano, Kenji Tsukigawa, Victor TG Chuang, Masaki Otagiri, and Keishi Yamasaki

From the link below, you can access the J-STAGE public screen and browse the latest issue and archive. https://www.jstage.jst.go.jp/browse/bpb/-char/en



